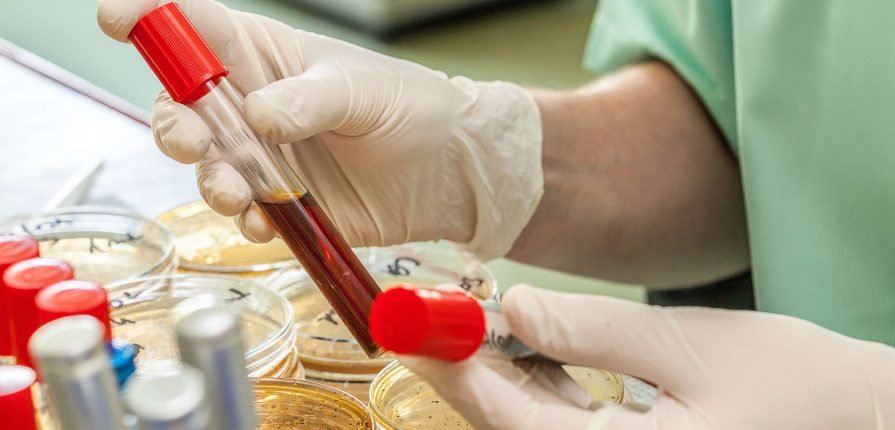

Distribuidor Exclusivo da RGCC no Brasil.
A RGCC é um laboratório de primeira classe na vanguarda da Oncologia Molecular na qual oferece análise das Células Tumorais Circulantes (CTC's) bem como Células-Tronco de Câncer (CSC's) localizada em Florina, Grécia.

R.G.C.C. - Research Genetic Cancer Center